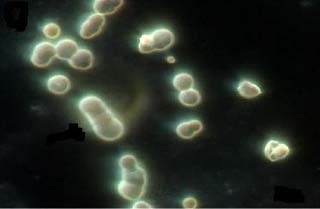
Vi khuẩn nano có phải là sinh vật sống hay không?

Sinh vật học
Sinh vật học
Khám phá những tin mới nhất về sinh vật học, khoa học về sự sống các loài động vật, thực vật kèm theo các hình ảnh tuyệt đẹp mới nhất về các loài động thực vật

Khác biệt về gen có liên quan đến sự hảo ngọt
Một nghiên cứu mới trên tờ Physiological Genomics đã phát hiện ra rằng những người có sự khác biệt về gen đặc trưng sẽ tiêu thụ thực phẩm có chất đường nhiều hơn. Cuộc nghiên cứu cung cấp bằng chứng đầu tiên về vai trò của sự khác biệt trong gen GLUT2 (một loại gen kiểm soát lượ
Đăng ngày: 16/05/2008

Nâng cao giá trị cây tràm
Các nhà khoa học thuộc Trường ĐH Bách khoa TPHCM vừa nghiên cứu hoàn chỉnh công nghệ chiết xuất tinh dầu tràm và than hoạt tính từ cây tràm. Lá tràm thường dùng để xông giải cảm, không có giá trị công nghiệp.
Đăng ngày: 15/05/2008

Cà chua kháng nấm
Các nhà khoa học thuộc trường đại học Amsterdam đã khám phá ra cách thức giữ cho cà chua khỏi bị héo nhũn – câu trả lời nằm trong mức độ phân tử. Bài báo về việc cây trồng làm thế nào để đánh bại mầm bệnh và điều này có ý nghĩa gì đối với việc chống lại những căn bệnh ở thực vật khác được công bố vào ngày 9 tháng 5 trên tạp chí trực tuyến PLo
Đăng ngày: 15/05/2008

Tuyệt vời cây lúa miến ngọt!
Ngọt như mía, trông giống như bắp, cực kỳ dễ trồng, không những có thể làm thực phẩm cho người, thức ăn cho gia súc, mà còn có thể làm nguyên liệu điều chế nhiên liệu sinh học, trong khi phần xác bỏ đi có thể dùng trong quá trình s
Đăng ngày: 15/05/2008

Các nghiên cứu trên chuột chính xác tới mức độ nào?
Chuột và người có bộ gen di truyền giống nhau 80%, khiến chuột trở thành đối tượng đóng thay phù hợp và có lợi cho con người trong nghiên cứu y khoa. Một bài báo gần đây bởi hai nhà sinh học của trường đại học Michigan Ben-Yang Liao và Jianzhi Zhan
Đăng ngày: 15/05/2008

Mốc bánh mỳ giữ bí quyết vô hiệu hóa gen gây bệnh
Đa số mọi người khi thấy bánh mỳ có mốc, họ đều bỏ nó đi. Phần trăm ít ỏi còn lại lại nhìn thấy một thế giới đầy tiềm năng của các loài nấm mốc bé nhỏ. Một nhà khoa học đại học Missouri cùng với nhóm cộng tác nghiên cứu đã t&igra
Đăng ngày: 11/05/2008

Xác định được gen giúp tăng sản lượng lúa
Các nhà khoa học Trung Quốc cho biết đã xác định được một gen đơn có vai trò quyết định đến sản lượng lúa cũng như chiều cao và thời gian ra hoa của cây lúa. Đây có thể xem là bước quyết định để tăng sản lượng lúa gạo.
Đăng ngày: 07/05/2008

Biến đổi nấm thành nhiên liệu: hứa hẹn năng lượng xanh sạch hơn
Đội ngũ các nhà nghiên cứu hàn lâm của chính phủ công bố rằng một loại nấm như nhện bám chặt vào đồng phục quân đội và các tấm lều vải bạt có thể giữ mấu chốt quan trọng đối với sự tiến bộ trong việc sản xuất các nhiên liệu sinh học.
Đăng ngày: 06/05/2008

Nấm nút chứa nhiều chất chống oxy hóa hơn những loại nấm đắt tiền khác
Loài nấm nút màu trắng nhỏ bé (nấm mỡ - Agaricus bisporus) có nhiều đặc tính chống oxy hóa hơn các loại nấm đắt tiền khác.
Đăng ngày: 06/05/2008

Lưu trữ DNA từ các loài cây trên thế giới
Vườn Thực Vật New York có thể được biết đến nhiều nhất về cảnh muôn hoa khoe sắc, nhưng các nhà nghiên cứu của khu vườn đang nỗ lực để thu giữ DNA từ hàng ngàn loài cây trên khắp thế giới.
Đăng ngày: 06/05/2008
Vi khuẩn nano có phải là sinh vật sống hay không?
Các phân tử cực nhỏ được gọi là vi khuẩn nano đã làm rối trí các nhà khoa học về nhiều mặt kể từ khi người ta phát hiện ra nó cách đây 20 năm, nhưng câu hỏi gây tranh cãi nhất mà nó đặt ra là liệu chúng có sống hay không.
Đăng ngày: 06/05/2008

Loài hoa lạ hồi sinh sau hơn 20 năm
Một nhà khoa học tại Vườn thực vật Missouri (Mỹ) đã tái phát hiện và nhận dạng một loài cây ký sinh hiếm hoi mà giới khoa học không hề nhìn thấy trong hơn 20 năm qua.
Đăng ngày: 03/05/2008

Cố định ni-tơ: mối quan hệ giữa thực vật và vi khuẩn (Phần 1)
Không khí gần như là một trò đùa. Không gì có thể chống lại oxy nhưng 78% không khí lại là ni-tơ. Ni-tơ thường là nguồn gốc sự sống trên trái đất và là nguồn dinh dưỡng quyết định sự vật phát triển đến mức nào, phát triển ở đâu. V
Đăng ngày: 03/05/2008

Gen bật, tắt tùy thuộc vào địa lý và lối sống
Ghi điểm trong cuộc tranh cãi giữa một bên là tự nhiên, một bên là sự nuôi dưỡng, các nhà di truyền học thuộc đại học North Carolina đã chứng minh rằng nhân tố môi trường như lối sống và địa lý giữ một vai trò lớn trong việc điều hành bật hoặc t
Đăng ngày: 02/05/2008

Hệ sinh thái cổ đại rất giống hệ sinh thái ngày nay
Đó là thế giới mà Anomalocaris khổng lồ chén thịt những con bọ ba thùy, góp mặt trong thế giới đó là những loài không còn tồn tại trên trái đất ngày nay. Nhưng theo các nhà nghiên cứu thực hiện công trình đầu tiên tái dựng lưới thức ă
Đăng ngày: 01/05/2008

Có thể nhân bản thiên tài từ tế bào da?
Công ty công nghệ sinh học ACT (Mỹ) vừa phát triển kỹ thuật có thể cho ra đời những em bé như ý muốn. Phương pháp này được cho hiệu quả hơn kỹ thuật nhân bản cừu Dolly trước đây và phù hợp hơn với người vì ít gây tác dụng phụ.
Đăng ngày: 29/04/2008
Tiêu điểm



